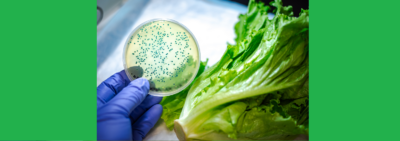

La newslettera di Doriella e Renato, con agenda e resoconti lotte e pensiero, continua nel 2025. In aggiornamento ininterrotto, sia l’Agenda sia gli Acta. Sotto il Moloch, per ora. Conoscete, fate conoscere!
video
I video di Trancemedia.eu collegano visioni che non possono più restare separate, pertanto costituiscono semilavorati di contenuti a venire. Per segnalare video, email info@trancemedia.staging.19.coop

da Ottolina TV: Marco Travaglio – perché i criminali che ci governano hanno voluto la guerra alla Russia

da L’Antidiplomatico: “La Siria si trasformerà in 5 piccoli paesini”. La previsione incredibile di Gheddafi
Sotto il Moloch
Nell'Occidente reale, il Moloch è il pensiero del danaro-debito-disastro cui si sacrificano le capacità cognitive dell'homo videns. Da sotto il Moloch, sussulti per una trance di ritorno. Alla realtà.
11 Marzo 2025 / di Doriella e Renato, la Newslettera in aggiornamento continuo (anno VI in Trancemedia.eu)
31 Dicembre 2024 / di La newslettera di Doriella e Renato, cronache dell'anno 2024, da dicembre scendendo a gennaio nella 'pagina lunga'
la newslettera di Doriella e Renato 2024, cronache di un anno di lotta e di pensiero
15 Dicembre 2024 / di redazione di Trancemedia, compilazione di testi del Parlamento Europeo, di Maria Zakharova e Mick Wallace, e di Altiero Spinelli, Ernesto Rossi, Eugenio Colorni. Aggiornamento con Emmanuel Macron. Commento alter-europeista della nostra redazione.
Il Parlamento Europeo alla ricerca d’ideologia sprofonda in Atlantico
31 Agosto 2021 / di XINHUA - People's Daily online (trad. it. a cura di Trancemedia.eu)
I sette peccati del sistema di alleanze degli USA – parte A
30 Agosto 2021 / di XINHUA - People's Daily online (trad. it. a cura di Trancemedia.eu)
I sette peccati del sistema di alleanze degli USA – parte B
8 Giugno 2020 / di Tiziana Ripani
Napoli non si vende
19 Aprile 2020 / di Redazione Trancemedia.eu - Compilazione di rapporti Assemblea21 : Debitour di Torino
Debitour di Torino appena prima del Covid: da Assemblea21, visioni realistiche per IL-DOPO – 1a parte
18 Aprile 2020 / di Redazione Trancemedia.eu - Compilazione di rapporti Assemblea21 : Debitour di Torino
Debitour di Torino appena prima del Covid: da Assemblea21, visioni realistiche per IL-DOPO – 2a parte
10 Febbraio 2020 / di Ufficio stampa Sara Cunial, Monica Di Sisto, Fabrizio Garbarino, Redazione Trancemedia.eu - con un intervento (2016) di Rossana Becarelli
NO allo zombie TTIP che avvelena la sovranità alimentare dell’Europa!
29 Maggio 2019 / di Claudio Papalia e Tiziana Ripani
CON QUALE DIRITTO – il film
30 Novembre 2018 / di Sergio Bologna
Grandi Opere per coprire magagne italiche
14 Novembre 2018 / di Maurizio Pagliassotti - 7
Torino, a bagno nell’Onda arancione, chiede le polveri
9 Novembre 2018 / di redazione Trancemedia.eu
I teologi della PERFORAZIONE e i loro OBIETTORI
5 Novembre 2018 / di Maurizio Pagliassotti - 6
Mappe concettuali IL GRANDE MECCANISMO DELLE GRANDI OPERE PUBBLICHE di Mario Cavargna. Infografiche di Eva Benso
Mappe concettuali IL GRANDE MECCANISMO DELLE GRANDI OPERE PUBBLICHE di Mario Cavargna. Infografiche di Eva Benso
Falso pensiero vs. progettazione sociale. Decidere.
14 Ottobre 2018 / di Maurizio Pagliassotti - 5
Dalle Ande alle Alpi Graie, un mo’ basta che arriva?
5 Ottobre 2018 / di redazione Trancemedia.eu
Finanza nel Mezzogiorno: brutalità estrattivista
2 Ottobre 2018 / di Claudio Papalia
Agroecologia: cibo cognitivo per un’altra umanità
29 Settembre 2018 / di redazione Trancemedia.eu
Il “centro di ricerca sotterraneo più grande del mondo” inquina l’acqua potabile di 700.000 umani? È il progresso, ET!
26 Settembre 2018 / di Maurizio Pagliassotti - 4
Nel quartiere che fu della Grandi Motori, l’Aurora di Torino, non abita Ronaldo
19 Settembre 2018 / di Maurizio Pagliassotti - 3
La paga della vigna, la françafrique nel bagagliaio, la pipì tra gli scaffali
Contenuti Altri
L'acquisto dei contenuti è sospeso. Grazie di leggere la pagina CONTATTA TRANCEMEDIA.EU
19 Giugno 2018 / di Ivan Cicconi, Claudio Giorno, Francesco Paola, Andrea Debenedetti (letture iniziali) e molti a seguire
TAV CHI SÌ
19 Giugno 2018 / di Autori Vari
NOI NO forzati fossili
Riunione Editori
Qui c'è l'invito di Trancemedia.eu agli Editori e ai Produttori indipendenti. Benvenuti per una discussione a più voci!
18 Febbraio 2024 / di Marilena Genovese per Candelaio di Giordano Bruno, 2022-2024
Marilena Genovese per CANDELAIO
21 Settembre 2020 / di redazione Trancemedia.eu
Sotto quale diritto sta finendo il West?
11 Settembre 2020 / di Claudio Papalia e Tiziana Ripani
CON QUALE DIRITTO, streaming dal Bellaria Film Festival – settembre 2020
11 Dicembre 2019 / di redazione Trancemedia.eu
La sperimentazione di Trancemedia.eu disponibile per Fert.org e i partner europei
la Cura
Notizie poco veicolate o molto travisate dal sistema dei media. Visioni e pratiche per curare le cause anziché truccare gli effetti dei disastri in atto. Senza pretesa di coperture organiche. Verbatim, o in originale dal sito editore. Anche in lingue diverse dall'italiano. Email: info@trancemedia.staging.19.coop
11 Marzo 2025
Non in nostro nome
10 Febbraio 2025
DeepSeek – digest dai media cinesi
4 Febbraio 2025
Cavallerizza torinese: i 5Stelle diventano Hotel
15 Dicembre 2024